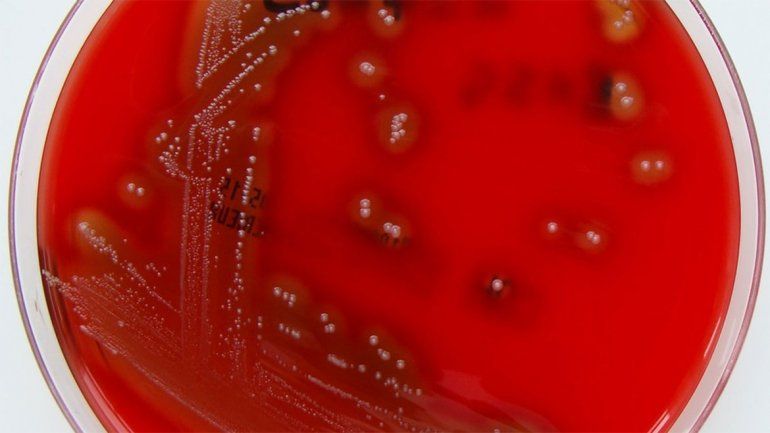
Ya son los cuatro los niños que murieron a causa de una bacteria

Ya son los cuatro los niños que murieron a causa de una bacteria
Una niña de seis años murió en Rosario como consecuencia de una infección por una bacteria, la cual también causó el deceso de otros dos menores en la Ciudad de Buenos Aires. En tanto, según confirmó la jefa de Infectología del Hospital Pediátrico de Posadas, una niña de seis años que estaba internada en el sanatorio Caminos afectada por esta bacteria perdió la vida el último sábado.
Las cuatro muertes fueron causadas por la bacteria streptococcus pyogene, por la cual otros tres niños se encontraban internados en estado grave en Buenos Aires.
Te puede interesar...
Liliana Benegas, infectóloga integrante del Área de Epidemiología de la provincia de Santa Fe, confirmó el deceso de la nena.
"Se trató del primer caso fatal en la provincia. Una nena de seis años y fue un caso fulminante", explicó la funcionaria en declaraciones reproducidas por el sitio del diario La Capital.
La Secretaría de Salud de la Ciudad de Buenos Aires emitió una alerta epimediológica como consecuencia de la aparición de la bacteria.
La medida fue tomada para para contener los brotes de la enfermedad causada por la bacteria Streptococcus pyogene, la cual produce angina con pus, placas e infecciones en la piel.
No obstante, el infectólogo Eduardo López, jefe del Departamento de Medicina del Hospital Ricardo Gutiérrez descartó que se trate de una "epidemia" y en cambio aseguró que se trataba de una "enfermedad rara".
Los pacientes que contrajeron la enfermedad en el área metropolitana de Buenos Aires fueron un bebé de 5 meses, y cuatro niños entre 3 y 7 años, según se informó, mientras que los fallecidos eran oriundos de Capital Federal y el vecino distrito bonaerense de Avellaneda.
Los tres niños que habían sobrevivido experimentaron mejoras en las últimas horas.
"Definitivamente esto no es una epidemia, se trata de una enfermedad con complicaciones graves pero que son raras. No hay vacuna preventiva para el estreptococo, pero si se realiza una consulta precoz y se diagnostica a tiempo, los síntomas se pueden tratar con antibióticos tipo penicilina", indicó en declaraciones al canal TN.
Según el experto, "es raro que esta bacteria pase a sangre" y remarcó que "si eso sucede puede impactar en varios órganos, que fue lo que sucedió en el caso de los chicos que murieron".
"La mortalidad oscila entre el 20 y el 30 por ciento", añadió el especialista.
López hizo hincapié en la higiene para prevenir la enfermedad y en acciones como lavarse las manos y cortarse las uñas, ya que el contagio es directo entre personas, y por las vías respiratorias.
También sostuvo que es importante el tratamiento tomado a tiempo, ya que el infectado que recibe penicilina deja de contagiar entre las 12 y las 24 horas posteriores.
LEÉ MÁS
Leé más
Cipolletti fue sede de un encuentro patagónico para integrar los sistemas sanitarios
Indignante agresión en la guardia médica: agredieron y amenazaron al personal
Noticias relacionadas
Lo más leído